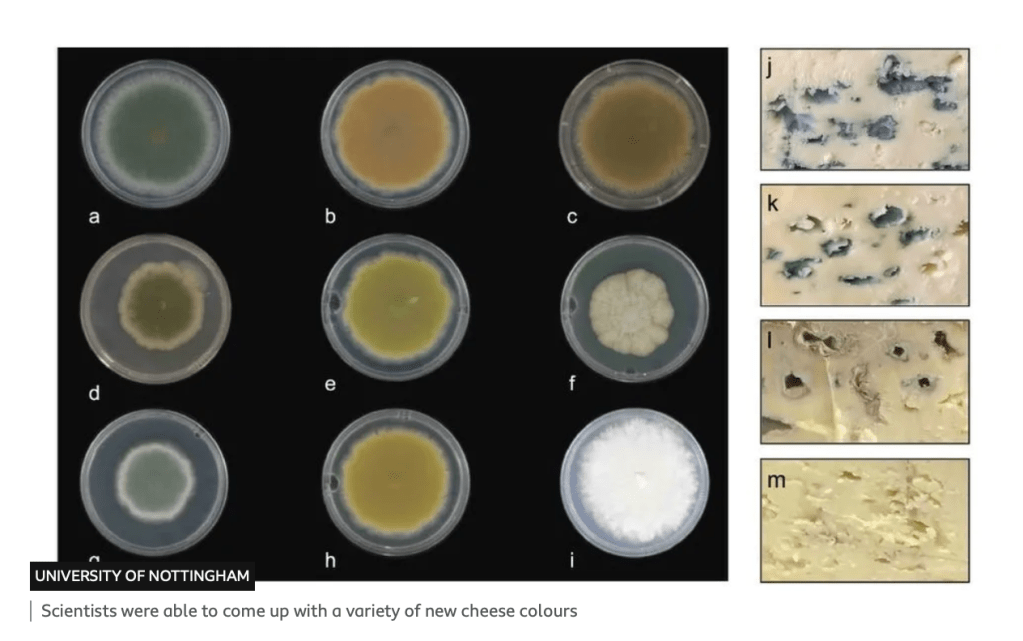

Universities are often being asked to demonstrate the real value of the research which they receive public funding for. There is substantial evidence about the impact of university research and innovation and the huge economic and social benefits this brings for the UK. However, the person in the street or on the (always surprisingly busy) Clapham omnibus still wants to know ‘what has all this research actually done to make my life better?’
Well, here is one answer: cheese from peas. It was recently announced that researchers at the University of Nottingham have come with a novel way to turn peas into cheese:
Alternative protein research exploring using peas to make sustainable plant-based cheese has received funding from Innovate UK to develop commercial processes for new products.‘Cheese from Peas’ is a new product being developed by researchers from the University of Nottingham and spin-out company The Good Pulse Company who are developing techniques to turn yellow peas grown in the UK into a sustainable plant-based cheese.This latest funding of over £300,000 from Innovate UK adds to over £370k in investment from UK’s leading scientific research organisation Rothamsted Research through their programme SHAKE Climate Change, and from leading food technology venture capital investors Big Idea Ventures. The grant has allowed the company to hire researchers from the university and also bring further expertise from other academics working on adjacent research areas.Dr Vincenzo di Bari, Assistant Professor in Food Structure and Processing at the University of Nottingham has been leading research that is looking for ways to develop a new generation of functional, minimally processed ingredients from legumes for applications such as plant-based cheese that is healthier and higher in proteins than existing cheese alternatives in the market.
The Good Pulse Company has already developed over 100 prototypes of plant-based cheese made from pulses using their proprietary technology and processes, as well as processes for making naturally gluten-free baked goods from pulses that are high in proteins and great in taste.
If you are of a certain age you might remember a mock advert from the Fast Show, a mid-90s sketch show, which promised an exciting new product for those who liked peas and liked cheese: cheesy peas.

For those with a nostalgic fondness for the Fast Show you can find the full advert here for Cheesy Peas. Who would have imagined this fictional product foreshadowed some real research impact over 25 years later.
New cheese colours
And even more recently, as reported on BBC Newsround, researchers have discovered how to make blue cheese into other colours.
There are many varieties of blue cheese that are produced around the world – including Stilton, Roquefort and Gorgonzola.
Although they might look and taste different, they are all made using the same fungus – Penicillium Roqueforti.
The unique flavour and blue-green colour come from the blue-pigmented spores formed as the fungus grows through the cheese.
However, experts at the University of Nottingham say they have discovered how the blue pigment is produced.
Scientists found that it actually starts off as a white colour, which progressively becomes yellow-green first, then red-brown-pink, dark brown, light blue – before finally reaching its final dark blue-green colour.
As a result, researchers say it is possible to stop the process along the way, resulting in a variety of new colours.
More cheese-related research with impact will be along soon I am sure.
Leave a comment